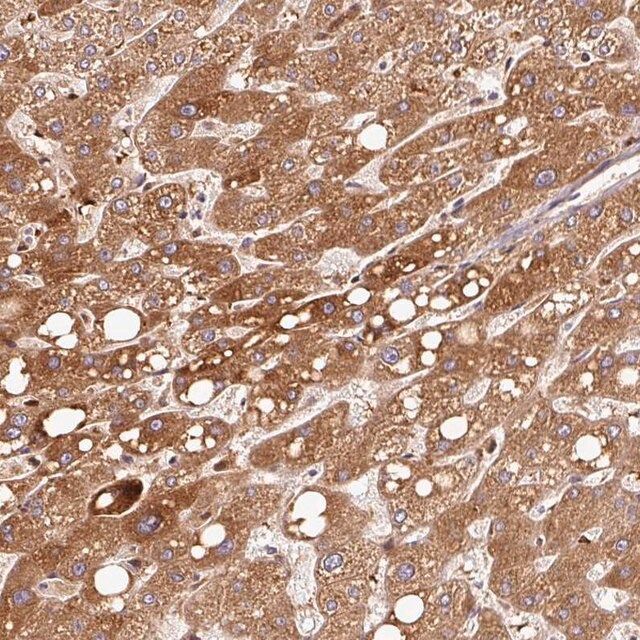

ن؛§ه“پن»‹ç»چï¼™ü/div>
ن؛§ه“پ说وکژ
ن¸€èˆ¬وڈڈè؟?/p>
The PFKM gene encodes the muscle isoform of phosphofructokinase (PFK) (ATP:D-fructose-6-phosphate-1-phosphotransferase, EC 2.7.1.11). PFK catalyzes the irreversible conversion of fructose-6-phosphate to fructose-1,6-bisphosphate and is a key regulatory enzyme in glycolysis. Mammalian PFK is a tetramer made up of various combinations of 3 subunits: muscle (PFKM), liver (PFKL; MIM 171860), and platelet (PFKP; MIM 171840), the genes for which are located on chromosomes 12q13, 21q22, and 10p, respectively. The composition of the tetramers differs according to the tissue type. Muscle and liver PFK are a homotetramers of 4M and 4L subunits, respectively. Erythrocytes contain both L and M subunits, which randomly tetramerize to form M4, L4, and M3L, M2L2, and ML3 hybrid forms of the holoenzyme (Vora et al., 1980 [PubMed 6444721]; Raben and Sherman, 1995 [PubMed 7550225]).[supplied by OMIM
Phosphofructokinase muscle (PFKM) is a subunit of the mammalian tetramer phosphofructokinase. It is encoded by the gene mapped to human chromosome 12q13.1. PFKM is expressed in muscle, red blood cells, thyroid and brain.
ه…چç–«هژü/p>
PFKM (NP_000280.1, 1 a.a. ~ 780 a.a) full-length human protein.
Sequence
MTHEEHHAAKTLGIGKAIAVLTSGGDAQGMNAAVRAVVRVGIFTGARVFFVHEGYQGLVDGGDHIKEATWESVSMMLQLGGTVIGSARCKDFREREGRLRAAYNLVKRGITNLCVIGGDGSLTGADTFRSEWSDLLSDLQKAGKITDEEATKSSYLNIVGLVGSIDNDFCGTDMTIGTDSALHRIMEIVDAITTTAQSHQRTFVLEVMGRHCGYLALVTSLSCGADWVFIPECPPDDDWEEHLCRRLSETRTRGSRLNIIIVAEGAIDKNGKPITSEDIKNLVVKRLGYDTRVTVLGHVQRGGTPSAFDRILGSRMGVEAVMALLEGTPDTPACVVSLSGNQAVRLPLMECVQVTKDVTKAMDEKKFDEALKLRGRSFMNNWEVYKLLAHVRPPVSKSGSHTVAVMNVGAPAAGMNAAVRSTVRIGLIQGNRVLVVHDGFEGLAKGQIEEAGWSYVGGWTGQGGSKLGTKRTLPKKSFEQISANITKFNIQGLVIIGGFEAYTGGLELMEGRKQFDELCIPFVVIPATVSNNVPGSDFSVGADTALNTICTTCDRIKQSAAGTKRRVFIIETMGGYCGYLATMAGLAAGADAAYIFEEPFTIRDLQANVEHLVQKMKTTVKRGLVLRNEKCNENYTTDFIFNLYSEEGKGIFDSRKNVLGHMQQGGSPTPFDRNFATKMGAKAMNWMSGKIKESYRNGRIFANTPDSGCVLGMRKRALVFQPVAELKDQTDFEHRIPKEQWWLKLRPILKILAKYEIDLDTSDHAHLEHITRKRSGEAAV
ç”ںهŒ–/ç”ںçگ†ن½œç”¨
Phosphofructokinase muscle (PFKM) functions as a rate-limiting enzyme in glycolysis. Aberrations in the gene expression cause Tarui disease and might also lead to non-insulin-dependent diabetes mellitus (NIDDM). Mutation of the gene might also increases the risk of susceptibility to breast cancer.
ه¤–ه½¢
Solution in phosphate buffered saline, pH 7.4
ه…چè´£ه£°وکژ
Unless otherwise stated in our catalog or other company documentation accompanying the product(s), our products are intended for research use only and are not to be used for any other purpose, which includes but is not limited to, unauthorized commercial uses, in vitro diagnostic uses, ex vivo or in vivo therapeutic uses or any type of consumption or application to humans or animals.
هں؛وœ¬ن؟،وپ¯
ن؛§ه“پو€§è´¨
| ç”ں物و¥و؛گ |
rabbit |
| è´¨é‡ڈو°´ه¹³ |
100 |
| هپ¶èپ”ç‰?/td> |
unconjugated |
| وٹ—ن½“ه½¢ه¼ڈ |
purified immunoglobulin |
| antibody product type |
primary antibodies |
| ه…‹éڑ† |
polyclonal |
| ه½¢ه¼ڈ |
buffered aqueous solution |
| هˆ†هگé‡ژü/td> |
antigen 85.2 kDa |
| species reactivity |
mouse, human |
| technique(s) |
western blot: 1 ¦جg/mL |
| NCBI登记هڈ¶ü/td> |
NM_000289 |
| UniProt登记هڈ¶ü/td> |
P08237 |
| è؟گ输 |
dry ice |
| ه‚¨هکو¸©ه؛¦ |
?20â„‚ü/td> |
| Gene Information |
human ... PFKM(5213) |
ه®‰ه…¨ن؟،وپ¯
| ه‚¨هکهˆ†ç±»ن»£ç پ |
12 - Non Combustible Liquids |
| WGK |
WGK 3 |
| é—ھ点(F) |
Not applicable |
| é—ھ点(C) |
Not applicable |
 m.cnreagent.com
m.cnreagent.com